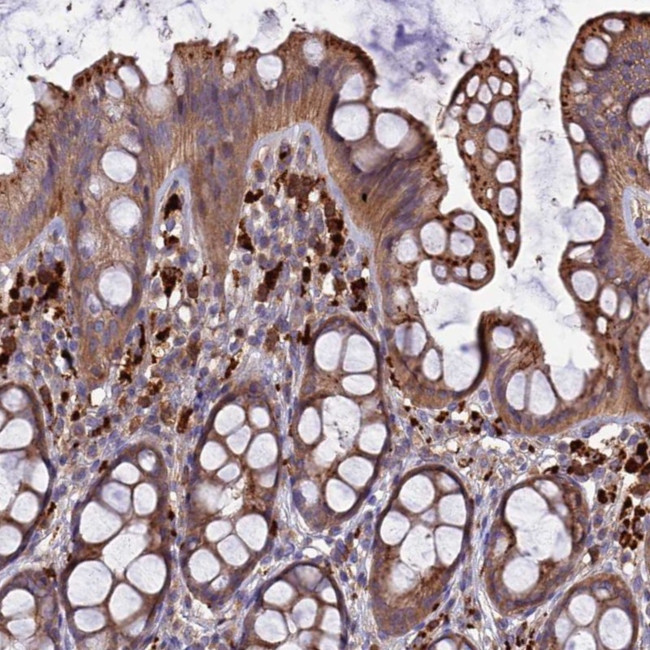
RLTPR Antibody in Immunohistochemistry (Paraffin) (IHC (P))

Search
Invitrogen
RLTPR Polyclonal Antibody
{{$productOrderCtrl.translations['antibody.pdp.commerceCard.promotion.promotions']}}
{{$productOrderCtrl.translations['antibody.pdp.commerceCard.promotion.viewpromo']}}
{{$productOrderCtrl.translations['antibody.pdp.commerceCard.promotion.promocode']}}: {{promo.promoCode}} {{promo.promoTitle}} {{promo.promoDescription}}. {{$productOrderCtrl.translations['antibody.pdp.commerceCard.promotion.learnmore']}}

Please note: We are reviewing Western blot images included in the antibody testing data in our catalog, including those provided by third parties. Unless expressly labeled or annotated as “raw-unedited”, Western blot images included in the antibody testing data in our catalog may have been edited, optimized or otherwise adjusted for presentation.
产品信息
PA5-59553
种属反应
宿主/亚型
分类
类型
抗原
偶联物
形式
浓度
规格
纯化类型
保存液
内含物
保存条件
运输条件
RRID
产品详细信息
Immunogen sequence: EVNELCQSVQ EHVELLGCGA GPQGEAAVRQ AEDAIQNANF SLSILPILYE AGSSPSHHWQ LGQKLEGLLR QVGEVCRQDI QDFTQ
Highest antigen sequence identity to the following orthologs: Mouse - 91%, Rat - 92%.
靶标信息
RLTPR/CARMIL2 (RGD motif, leucine rich repeats, tropomodulin domain and proline-rich containing; capping protein regulator and myosin 1 linker 2), also known as LRRC16C, is a cytosolic protein, which with high affinity binds CAPZA2 (capping protein muscle actin Z-line alpha 2) and decreases CAPZA2 affinity for actin barbed ends. RLTPR/CARMIL2 increases the rate of actin filament elongation from seeds in the presence of CAPZA2, however, seems unable to nucleate filaments. Its interaction with CAPZA2 is essential for lamellipodial protrusion and cell translocation. RLTPR/CARMIL2 is crucial for T cell costimulation via CD28 and this property seems to be independent on its actin-uncapping function. The lack of functional RLTPR/CARMIL2 molecules impeded the differentiation toward Th1 and Th17 fates of both human and murine CD4+ T cells and leads to combined immunodeficiency. Expression of RLTPR/CARMIL2 was also detected in human and murine B cells, but it seems not to be involved in BCR-mediated signaling.
仅用于科研。不用于诊断过程。未经明确授权不得转售。
篇参考文献 (0)
生物信息学
蛋白别名: Capping protein regulator and myosin 1 linker 2; Capping protein, Arp2/3 and myosin-I linker protein 2; F-actin-uncapping protein RLTPR; Leucine-rich repeat-containing protein 16C; RGD, leucine-rich repeat, tropomodulin and proline-rich-containing protein
基因别名: CARMIL2; LRRC16C; RLTPR
Entrez Gene ID: (Human) 146206